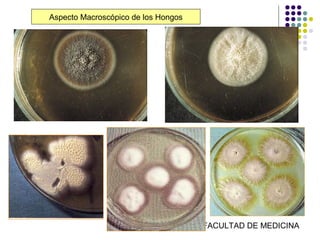
Aspecto Macroscópico de los Hongos




                FUNDACION BARCELO FACULTAD DE MEDICINA

El documento proporciona una visión general de los hongos, describiendo su clasificación, características estructurales y funciones biológicas, así como detalles sobre su nutrición y reproducción. También aborda la taxonomía, el dimorfismo, los métodos de diagnóstico micológico y los mecanismos de patogenicidad, junto con la acción de los antifúngicos y los tipos de resistencia a estos. Se destacan las interacciones de los hongos con su entorno y los aspectos relevantes de su biología y aplicación médica.